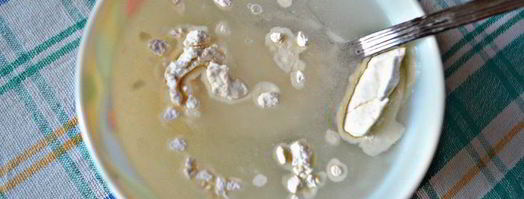
тефтели с грибами в томатном соусе. Шаг 7

Тефтели с грибами в томатном соусе
- Простой рецепт тефтелей
- Время приготовления: 1 ч 30 мин
- Порций: 6
- Калорий: 192 ккал
- Рецепт домашней кухни
Предлагаю вам приготовить очень вкусное, сытное и уютное блюдо для семейного обеда или ужина.
Любите готовить тефтели? Попробуйте рецепт куриных тефтелей в томатнома соусе. Должно понравиться.

Фото тефтелей с грибами в томатнома соусе.
Приготовление
-
Нам понадобится 0,5 ст (100г) отварного риса.
-
Подготовьте мясной фарш (у меня свинина + говядина).

-
Измельчите лук, очистите и порежьте грибы, с помощью пресса измельчите чеснок.

-
Сыр твердых сортов (у меня - Джугас) натрите на мелкой терке, укроп мелко порубите. К фаршу добавьте рис, лук с чесноком, грибы, укроп, посолите и поперчите по вкусу.

-
Все хорошо вымешайте. Руки смочите холодной водой и сформируйте из полученного фарша тефтели. Форму для запекания смажьте растительным маслом и выложите в нее тефтели.

-
Для соуса к томатному соку добавьте сахар, сметану и перемешайте, а при необходимости - подсолите.

-
Муку перемешайте с 0,5 стакана холодной воды и хорошо размешайте, чтобы не было комочков. Затем соедините с томатно-сметанной смесью.

-
Тефтели залейте получившимся соусом. Форму с тефтелями накройте фольгой и запекайте в разогретой до 180г духовке в течение 50 мин - 1ч.

-
Готовые тефтели подавайте со спагетти или картофелем, полив обильно томатным соусом и посыпав рубленной зеленью. Приятного вам аппетита!

На заметку
Главное не опускать руки, тогда всё получится. Чаще готовьте, не теряйте форму. Советую тефтели в мультиварке, в томатном соусе с розмарином. Всегда стараюсь приготовить что-нибудь новое.
Ингредиенты на
- шампиньоны - 250 г
- сыр - 50 г
- лук репчатый - 1 шт.
- чеснок - 1 зубчик
- рис - ½ стак.
- томатный сок - 1 стак.
- мука - 2 ст.л.
- сметана 20% - 3 ст.л.
- растительное масло - 1 ст.л.
- соль - по вкусу
- сахар - 1 ч.л.
- перец черный свежемолотый - по вкусу
- укроп свежий - 3 веточки
- мясной фарш - 300 г
Тефтели
фарш мясной 400 г • яйца перепелиные 5-6 шт. • сметана 100 г • вода 100 г...


Тефтели
Тефтели мы ели и в садике, и у бабушки в деревне, и дома. Когда находишься вдали от родных стен, часто хочется чего-нибудь домашнего. Вот, как приготовить тефтели с моцареллой в томатном соусе....
Тефтели
Гречневая каша необычайно полезна, крупа способна поддерживать зрение, мозговое кровообращение, очищать сосуды. Но что делать, если вы или ваши домашние не любят гречневую кашу? Приготовьте тефтели....


Тефтели
Меня тут всячески упрекают в дефиците рыбных блюд (Darya%-), привет ;. Сегодня я восполняю пробел и делюсь рецептом марокканских рыбных фрикаделек. Для их приготовления подходит любая белая морская рыба...

Рубленые тефтели в томатном соусе
Тефтели
Комментарии к рецепту
Сейчас пойду готовить)))
Приготовила тефтели с грибами в томатном соусе…шедеврально!
Домашние были в восторге.
Спасибо!
Всегда делала почти по такому же рецепту, но чуть в иных пропорциях — было вкусно.
Но по Вашему рецепту — ИЗУМИТЕЛЬНО!!!
Совет всем: делая первый раз, не отступайте от рецептов.
И только попробовав, в следующий раз вносите свои изменения!!!
Виноградовых, большое спасибо за рецепт!!!
Восторгу нет предела!
Все получилось очень вкусно.
Виноградовых, спасибо большое за рецепты!
Я ваша поклонница, готовлю многие ваши рецепты!
Все СУПЕР!!!
тефтели с грибами в томатном соусе приготовила вчера!
СПАСИБО!!!
Вот здесь по ссылке вы найдете замечательный рецепт мясных тефтелей с рисом и овощами в томатном соусе.
Спасибо, рецептик замечательный
За рецепт спасибо
Благодарю за рецепт))
Он помог сделать приятно любимому))
Делала уже 2 раза за последнюю неделю.
Решила просто попробовать, но вышло вкуснее ожидаемого!
Виноградовых, спасибо вам огромное за этот прекрасный рецепт!!!
Приготовила эту вкуснятину, так домашние не поверили, что я сама делала, а не покупала!
Очень хороший сайт.Умница!
Все просто изложено, красиво и доходчиво,с фото.Слов нет.
Одно удовольствие, готовь только и всего!
Спасибо!
Я раньше каждый раз делала по разному, но сейчас было особенно вкусно!!!
Как же хочется тефтелей с грибами в томатном соусе!!!
Очень вкусно! Всем гостям понравилось.
Виноградовых, ВСЕ-ВСЕ очень вкусно!
получилось идеально…
Тефтели с тыквой в томатном соусе
Тефтели